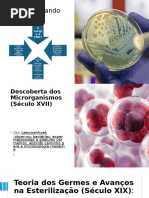

100% acharam este documento útil (1 voto)
208 visualizações30 páginas2021 CME Recepção Expurgo
O documento descreve os processos de recepção e expurgo de materiais em uma área hospitalar, incluindo a limpeza manual de instrumentos e equipamentos, os diferentes tipos de água utilizados nesse processo e as etapas de crescimento e morte microbiana.
Enviado por
Mariane AndradeDireitos autorais
© © All Rights Reserved
Levamos muito a sério os direitos de conteúdo. Se você suspeita que este conteúdo é seu, reivindique-o aqui.
Formatos disponíveis
Baixe no formato PPTX, PDF, TXT ou leia on-line no Scribd
100% acharam este documento útil (1 voto)
208 visualizações30 páginas2021 CME Recepção Expurgo
O documento descreve os processos de recepção e expurgo de materiais em uma área hospitalar, incluindo a limpeza manual de instrumentos e equipamentos, os diferentes tipos de água utilizados nesse processo e as etapas de crescimento e morte microbiana.
Enviado por
Mariane AndradeDireitos autorais
© © All Rights Reserved
Levamos muito a sério os direitos de conteúdo. Se você suspeita que este conteúdo é seu, reivindique-o aqui.
Formatos disponíveis
Baixe no formato PPTX, PDF, TXT ou leia on-line no Scribd